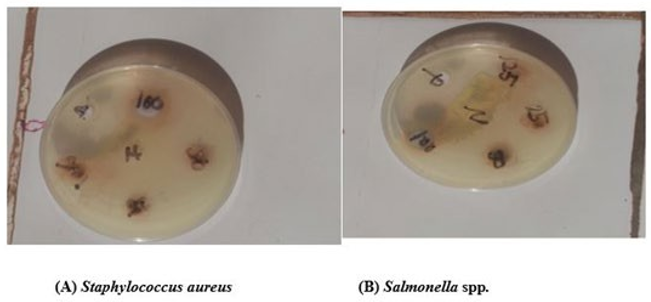

Research Article - (2024) Volume 3, Issue 1
Antimicrobial Activity of Jatropha Curcas Sap on Selected Microorganisms
2Department of Science Laboratory Technology, Kogi State Polytechnic, Nigeria
3Department of Microbiology, Federal University of Technology, Nigeria
Received Date: Feb 01, 2024 / Accepted Date: May 05, 2024 / Published Date: Mar 14, 2024
Copyright: ©Â©2024 Zakari David Adeiza, et al. This is an open-access article distributed under the terms of the Creative Commons Attribution License, which permits unrestricted use, distribution, and reproduction in any medium, provided the original author and source are credited.
Citation: Adeiza, Z. D., Olaitan, C. O., Emmanuel, E., Israel, O. A., Danjuma, S. Y. (2024). Antimicrobial Activity of Jatropha Curcas Sap on Selected Microorganisms. J Traditional Medicine & Applications, 3(1), 01-06.
Abstract
Jatropha curcas sap is used for medicinal purposes.It has played a major role in the treatment of various diseases including bacterial and fungal infections.This study evaluated the antimicrobial activity of Jatropha curcas sap against selected microorganisms (Shigella spp, Staphylococcus aureus, Salmonella spp,Candida albicans and Trichophyton spp) using standard procedures.The qualitative phytochemical screening of the sap reveals the presence of saponins, alkaloids, flavonoids,tannins, carbohydrate, glycosides while Steroids was absent. It was observed that the test organisms were more susceptible at high concentration which is 100. The highest zone of inhibition for bacteria was observed on Staphylococcus aureus and the lowest zone of inhibition was on Salmonella sp. For fungi the highest zone of inhibition was on Candida albicans and the lowest zone of inhibition was on Trichophyton sp. There was no zone of inhibition for water which serves as negative control. But there was zone of inhibition for the positive controls which were Ciprofloxacin and Ketoconazole. Jatropha curcas sap is a potential antimicrobial substance, active against Gram negative and Gram-positive bacteria and some fungi. It is therefore a potential antimicrobial agent.
Keywords
Jatropha Curcas, Shigella Spp, Staphylococcus Aureus, Salmonella Spp, Candida Albicans, Trichophyton Spp
Introduction
Anti-microbial agents are substances that kill microorganisms or inhibit their growth. They are widely employed to cure bacterial diseases. Antimicrobial agents that reversibly inhibit growth of bacteria are called bacteriostatic whereas those with irreversible lethal action on bacteria are known as bactericidal [1]. Ideally, antimicrobial agents disrupt microbial processes or structures that differ from those of the host. They may damage pathogens by hampering cell wall synthesis, inhibiting microbial protein and nucleic acid synthesis, disrupting microbial membrane structure and function, or blocking metabolic pathways through inhibition of key enzymes reported that plant extracts and their products are used in many parts of the world as the active principles in herb remedies [2]. They are used locally in the treatment of infections, many centuries before scientific studies were discovered. Plants derivatives have made a large contribution to human health as they have been used as source of preliminary compound of drugs.
Widespread usages of drugs have led to the development of pathogen resistance, hence, urging research of new drugs for the treatment of diseases. Active compound present in the medicinal plants provide the bountiful resource of active compounds for the pharmaceutical, cosmetics and food industries, and more recently in agriculture for pest control.
According to the world health organization (WHO), over 80 percent of the world’s population especially in the developing world relies on medicinal plants as sources of medicines for their primary healthcare. Traditional system of medicine which depends mainly on medicinal plants is rich in ethnomical knowledge of the uses of medicinal plants in the treatments of infectious conditions. These medicinal plants employed in traditional medicine represents potential sources of cheap and effective standardized herbal medicines (phytomedicine) and leads in the discovery of novel molecules for the development of new chemotherapeutic agents [3]. Several infectious diseases including malaria, diarrhea, dysentery, gonorrhea, and fungal infections have been successfully managed in traditional medical practice employing medicinal plants [4].
Jatropha curcas plant originated from Mexico and was spread to Asia and Africa by Portuguese traders as a hedge plant and it belongs to the family Euphorbiaceae. In many subtropical and semi-arid regions. traditionally, J. curcas is used for its medicinal properties and its seeds contain semi-dry oil which has been found to be useful for medicinal purposes. It has played a major role in the treatment of various diseases including bacterial and fungal infections. The seeds and leaves extract of J. curcas, have shown molluscidal and insecticidal properties. The extracts of many Jatropha species including J. curcas have shown to display potent cytotoxic, anti-tumour and antimicrobial activities in different assays. The latex of J. curcas have shown to possess antibacterial activity against Staphylococcus aureus [5]. However, the antimicrobial activity of the other parts has not been fully investigated.
The plant has thick glabrous branches, straight trunk and grey or reddish bark, masked by large white patches. It has green leaves with short shallow lobs, which are alternately arranged [6]. J. curcas is widely used in traditional medicine in Africa, Asia and Latin America to cure various ailments such as skin infections, diarrhea, gonorrhea, fever and several other diseases caused by microorganisms [7]. J. curcas has also been used as antidote, remedy, medicine and potential source of herbal drugs in dental complaints and against constipation [8]. Sap (latex) is applied directly to wounds and cuts as a styptic and astringent to clean teeth, gums, and to treat sores on the tongue and in the mouth, it has coagulating effects on blood plasma. The sap also used as a remedy for alopecia, anasorca, burns, dropsy, eczema, inflammation, paralysis and yellow fever. The sap is also used for the treatment of dermatomycoses diseases [9].
Materials and Methods
Profile of the Study Area
The study area is Anyigba town, Dekina Local Government Area, Kogi State. This area falls within the tropical wet and dry climate region. The latitude: 7015-7029N and Longitude: 7011- 7032. The daily temperature range is 25-300C [10].
Collection and Preparation of the Plant Sap
The Jatropha curcas sap was collected from different locations in Anyigba, Kogi State in the month of May, 2022 and was authenticated at the Department of Biological Sciences, Prince Abubakar Audu University, Anyigba, Nigeria. The plant sap from J. curcas was collected directly into microfuge tubes after leaf and stem cutting and kept refrigerated at 4oC.
Sterilization of Glass Wares and Media
All glass wares were thoroughly washed with the detergent and rinsed with distilled water. They were dried in the hot air oven and then sterilized at a temperature of 121oC for fifteen minutes using the autoclave. The media was prepared according to the manufacturer’s instructions and sterilized by autoclaving also at 121oC for fifteen minutes. Alcohol was used to disinfect the benches before any experiment was carried out to avoid contamination and to ensure asceptic working condition.
Phytochemical Screening of J Curcas Sap
The J. curcas sap was qualitatively analysed for the presence of flavonoids, Saponins, carbohydrates, glycosides, steroids, tannins, and alkaloids in accordance with Trease and Evans (2004).
Antimicrobial Screening Test
Pure clinical isolates of Candida albicans, Trichophyton sp, Staphylococcus aureus, Salmonella sp and Shigella sp was obtained from the Microbiology Department Laboratory unit of Prince Abubakar Audu University (PAAU). The organisms were grown on a Nutrient Agar in an incubator at 37oC for 24 hours. The antimicrobial activity of J. curcas was measured by culture media using Mueller Hinton Agar.
Preparation of Mueller Hinton Agar
38g of Mueller Hinton Agar was weighed using weighing balance machine. It was dissolved in 1liter of distilled water. It was then heated to dissolved the media completely. The media was sterilized by autoclaving at 121oC for 15 minutes. It was allowed to cool to 45-500C. It was mixed and poured into sterile petri dishes.
Inoculation
The organisms used in the culture were as follows: Candida albicans, Trichophyton rubrum, Staphylococcus aureus, Salmonella sp and Shigella sp
Antimicrobial Susceptibility Assay
The agar well diffusion method was employed to determine the growth inhibition abilities of the test organisms by the sap. The 24hours old cultures were transferred into nutrient broth and incubated at 37°C for 5 hours and standardized to Mcfarland standard. A 0.5 mc farland Standard was prepared by mixing 0.05ml of 1.175% barium chloride dehydrate Bacl2.2H2O), with 9.95 ml of 1% sulfuric acid (H2SO4) and was compared visually with a suspension of bacteria and fungi in sterile nutrient broth. The concentration of 12.5, 25, 50 and 100 ml/ml was used and Mueller - Hinton agar was prepared and 30ml each was poured into sterile petri dishes. The agar was allowed to solidify and dry. The agar was aseptically inoculated uniformly with the test organism by flooding with 0.2 ml suspension of (106 cfu) which equivalent (0.5 McFarland) standard the test culture was preserved undisturbed for 30 minutes. Each of the test organisms from the broth cultures were streaked on 10 different Mueller Hinton agar plates under aseptic condition and were labeled accordingly with the aid of a sterile 6mm diameter cork-borer, five wells were borne on the agar sufficiently separated and kept at least 15 mm from the edge of the plate and 25 mm from well to well to prevent overlapping of zones. With the aid of a micropipette 0.2 ml of a known concentration of the sap at different concentrations were introduced into separate labelled wells (holes). This was done in duplicates and inoculated plates were incubated at 37 ºC for 24 hours. With the aid of a meter rule, the zone diameters of inhibition were measured and recorded to the nearest millimetre. Ciprofloxacin and Ketoconazole was used as the positive control while water was used as negative control.
Minimum Inhibitory Concentration (MIC)
The MIC of isolates was carried out using tube dilution technique as described by Doughari et al. The McFarland standard (106 cfu/ ml) was used to standardize the concentration of test organisms. A tube containing 2 ml of 18 hrs nutrient broth without extract was seeded with a loopful of the test organism previously diluted to 0.5 McFarland standard to serve as the positive control while a tube containing 2 ml of 18 hrs nutrient broth that was not inoculated served as the negative control. After incubation for 24 hours at 37oC, the tubes were then examined for microbial growth (turbidity).
Minimum Bactericidal Concentration (MBC)
The MBC is the lowest concentration of antibacterial substance required to produce a sterile culture. In this technique, the content of the test tube resulting from MIC was streaked using a sterile wire loop on agar plate and incubated at 370C for 24 hours. The lowest concentration of the sap which showed no bacterial growth was noted and recorded as MBC.
Minimum Fungicidal Concentration (MFC)
The MFC is the lowest concentration of antifungal substance required to produce a sterile culture. In this technique, the content of the test tube resulting from MIC was streaked using a sterile wire loop on agar plate and incubated at 370C for 24 hours. The lowest concentration of the sap which showed no fungi growth was noted and recorded as MFC.
Results
Table 1 shows the result of the phytochemical screening. It was observed that J. curcas sap was positive for alkaloids, flavonoids, carbohydrates, glycosides, saponinsand tanins while steroids were absent.
|
S/N |
Phytochemicals Constituents |
Qualitative Analysis |
|
1 |
Alkaloids |
+ |
|
2 |
Flavonoids |
+ |
|
3 |
Carbohydrate |
+ |
|
4 |
Glycosides |
+ |
|
5 |
Saponins |
+ |
|
6 |
Steroids |
- |
|
7 |
Tannins |
+ |
|
KEY: Positive = + Negative = - |
||
Table 1: Qualitative Phytochemicals Analysis of Jatropha Curcas Sap
Table 2 shows the result of antibacterial activity of J. curcas sap at different concentrations of 100ml/ml, 50ml/ml, 25ml/ml and 12.5ml/ ml. The inhibitory zone diameter on test bacterial isolates expressed at various concentrations of the sap ranges from 5mm to 25mm. Shigella sp, Staphylococcus aureus and Salmonella sp were all sensitive to the sap.
|
|
Sap concentration (ml/ml) |
Controls |
||||
|
Test organisms |
12.5 |
25 |
50 |
100 |
Ciprofloxacin (positive control) |
Distilled water (negative control) |
|
Inhibition zone diameter (mm) |
||||||
|
Salmonella spp. |
5 |
13 |
18 |
21 |
48 |
0 |
|
Shigella spp. |
12 |
14 |
17 |
20 |
30 |
0 |
|
Staphylococcus spp. |
9 |
12 |
16 |
25 |
46 |
0 |
Table 2: Inhibitory Zone Diameter of Jatropha Curcas Sap on Test Bacterial Isolates
Table 3 shows the result of antifungal activity of J. curcas sap at different concentrations of 100ml/ml, 50ml/ml, 25ml/ml and 12.5ml/ml. The zones of inhibition expressed at various concentrations of the sap shows that both Candida albicans and Trichophyton rubrum were all sensitive to the sap but Candida albicans was more sensitive and has the highest zone of inhibition.
|
|
Sap concentration (ml/ml) |
Controls |
||||
|
Test organisms |
12.5 |
25 |
50 |
100 |
Ketoconazole (positive control) |
Distilled water (negative control) |
|
Inhibition zone diameter (mm) |
||||||
|
Candida albicans |
15 |
19 |
21 |
26 |
32 |
0 |
|
Trichophyton spp. |
13 |
16 |
20 |
23 |
17 |
0 |
Table 3: Iinhibitory Zone Diameter of Jatropha Curcas Sap on Test Fungi Isolates
Table 4 shows the Minimum Inhibitory Concentration [MIC] and Minimum Bactericidal Concentration [MBC] of J. curcas sap against test organisms.
|
Test organisms |
MIC (ml/ml) |
MBC (ml/ml) |
|
Salmonella spp. |
25 |
25 |
|
Shigella spp. |
25 |
50 |
|
Staphylococcus spp. |
12.5 |
25 |
Table 4: Minimum Inhibitory Concentration and Minimum Bactericidal Concentration of Jatropha Curcas Against Test Organisms
Table 5 shows the Minimum Inhibitory Concentration [MIC] and Minimum Fungicidal Concentration [MFC] of J. curcas sap against test organisms.
|
Test organisms |
MIC (ml/ml) |
MFC (ml/ml) |
|
Candida sp. |
25 |
25 |
|
Trichophyton sp. |
12.5 |
50 |
Table 5: Minimum Inhibitory Concentration and Minimum Fungicidal Concentration of Jatropha Curcas Against Test Organisms
Zones of Inhibition Observed
Figure 1: (A) Staphylococcus aureus (B) Salmonella spp
Figure 2: (A) Shigella spp (B) Candida albicans
Discussion
The J. curcas sap was found to have antibacterial and antifungal effect against all the selected organisms used in this project work. (Staphylococcus aureus, Shigella spp, Salmonella spp, Candida albicans and Trichophyton rubrum). The most susceptible organism to the sap appeared to be staphylococcus aureus. (Thomas) also reported that J. cruces have shown to possess antibacterial activity against Staphylococcus aureus and have played a major role in the treatment of various diseases including bacterial and fungi. The susceptibility of staphylococcus aureus, Salmonella typhimurium and Shigella spp to the sap strengthens the suggestion that is could be useful for eczema and treatment of dermatomycoses diseases [9].
The qualitative phytochemical analysis indicated the presence of secondary metablolites. This finding agreed with the previous work of Trease et al., who reported the presence of flavonoids, tannins, carbohydrate, glycosides and sapponins in J. curcas sap which support the traditional medical uses of the sap in the treatment of different infection. The antimicrobial activity of J. curcas sap inhibited Staphylococcus aureus, Salmonella spp., Shigella spp., Candida albicans and Trichophyton rubrum with very small zone of inhibition. The minimum inhibitory concentration (MIC) and Minimum Bactericidal Concentration (MBC) shows inhibition at concentration (25ml/ml) and (50ml/ml).
The Minimum Fungicidal Concentration shows inhibition at concentration (50ml/ml). The highest zone of inhibition of J. curcas sap for bacterial isolates was observed on Staphylococcus aureus, and lowest zone of inhibition was observed on Shigella spp. While the highest zone of inhibition observed for fungi isolate was Candida albicans, and the lowest zone was observed on Trichophyton spp. Which shows that J. curcas sap can cure both bacterial and fungal infections. The antimicrobial screening showed the the sap was active against all the test organisms at 100ml/ml which was the highest concentration. Staphylococcus aureus, Salmonella spp, Shigella spp, Candida albicans and Trichophyton rubrum was 25mm, 21mm, 20mm, 26mm, and 23mm respectively.
At 50ml/ml Staphylococcus aureus, Salmonella spp, Shigella spp, Candida albicans and Trichophyton rubrum was 16mm, 18mm, 17mm, 21mm, and 20mm respectively. At 25ml/ml Staphylococcus aureus, Salmonella spp, Shigella spp, Candida albicans and Trichophyton rubrum was 12mm, 13mm, 14mm, 19mm, and 16mm respectively. At 12.5 ml/ml Staphylococcus aureus, Salmonella spp, Shigella spp, Candida albicans and Trichophyton rubrum was 9mm, 5mm, 9mm, 15mm, and 13mm respectively.
Conclusion
Based on the result of this study J. curcas is a potential antimicrobial substance active against Gram negative and Gram positive bactateria and some fungi. It also shows that sap can be useful in the treatment of skin diseases cause by Staphylococcus aureus, Salmonella spp., Shigella spp., Candida albicans it is therefore a potential antibiotic.
References
- Rajesh, B. and Rattan, L. I. (2008). Essentials of Medical Microbiology. 4th Edition. Jaypee Brothers Medical Publishers (P) Ltd. New Delhi 110002, India. pp. 500.
- Willey, J. M., Sherwood, L. M., & Woolverton, C. J. (2008).Prescott, Harley, and Klein’s microbiology. McGraw-Hill.
- Iwu, M. M. (1993). Handbook of African Medicinal plants CRC press. Boca Raton, FL, 183-184.
- Sofowora, A. (1993). Medicinal plants and traditional medicine in Africa. Spectrum Books Limited. Ibadan, Nigeria, 1-153.
- Thomas, O. O. (1989). Re-examination of the antimicrobial activities of Xylopia aethiopica, Carica papaya, Ocimum gratissimum and Jatropha curcas.
- Samba, A. N. S., Bassirou, D., Moustapha, D., Marone, D., Abdou, S. S. and Massaer, N. (2006). Jatropha curcas: Seed germination and propagation methods Institut Sénégalais de Recherches Agricoles (ISRA) – Laboratoire. National des Recherches sur les Productions Végétales (LNRPV). Route des Hydrocarbures, Bel-Air, BP 3120 Dakar: 134-224.
- Mishra, S. B., Vijayakumjar, M., Ojha, S. K., & Verma, A. (2010). Antidiabetic effect of Jatropha curcas L. leaves extract in normal and alloxan-induced diabetic rats. Int. J. Ph. Sci, 2(1), 482-487.
- Awe, A. B., Baiyewu, R. A., Fatade, B. O., Adeleke, T. O., Omidran, M. B., & Salaudeen, G. T. (2010, April). Phytochemical and antimicrobial evaluation of the leaves of Jatropha curcas. In Proceedings of the 2nd biennial National Conference of the Forests and Forest Products Society held at the Federal University of Technology, Akure, Nigeria between 26th and 29th of April (Vol. 2010, pp. p445-449).
- Dada, E. O., Ekundayo, F. O., & Makanjuola, O. O. (2014). Antibacterial activities of Jatropha curcas (LINN) on coliforms isolated from surface waters in Akure, Nigeria. International Journal of Biomedical Science: IJBS, 10(1), 25.
- Olarewaju Oluseyi, I., Salihu Danlami, M., & John Olusegun,A. (2011). Managing land use transformation and land surface temperature change in Anyigba Town, Kogi State, Nigeria. Journal of Geography and Geology, 3(1), 77-85.

